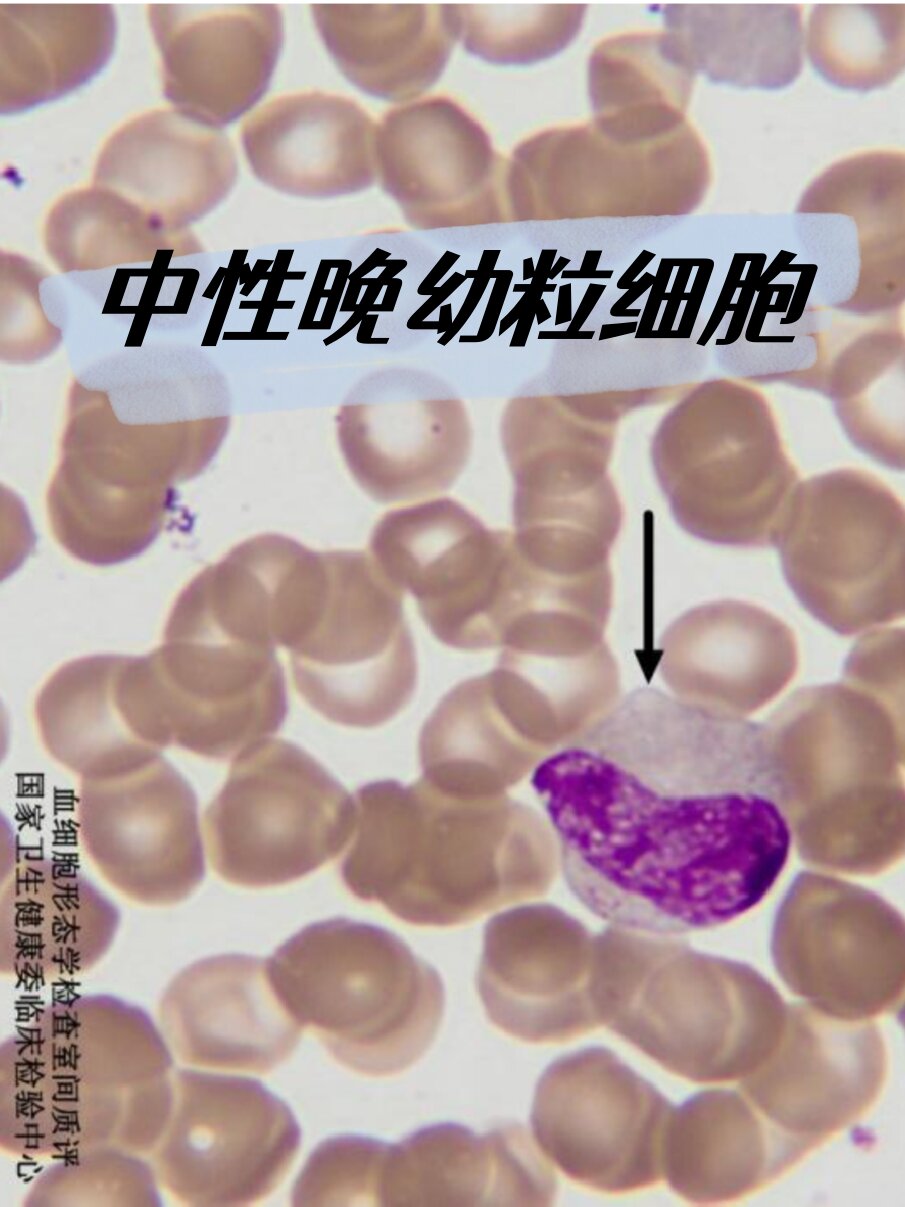
—血细胞形态学检查 👉  	 🍀中性晚幼粒细胞
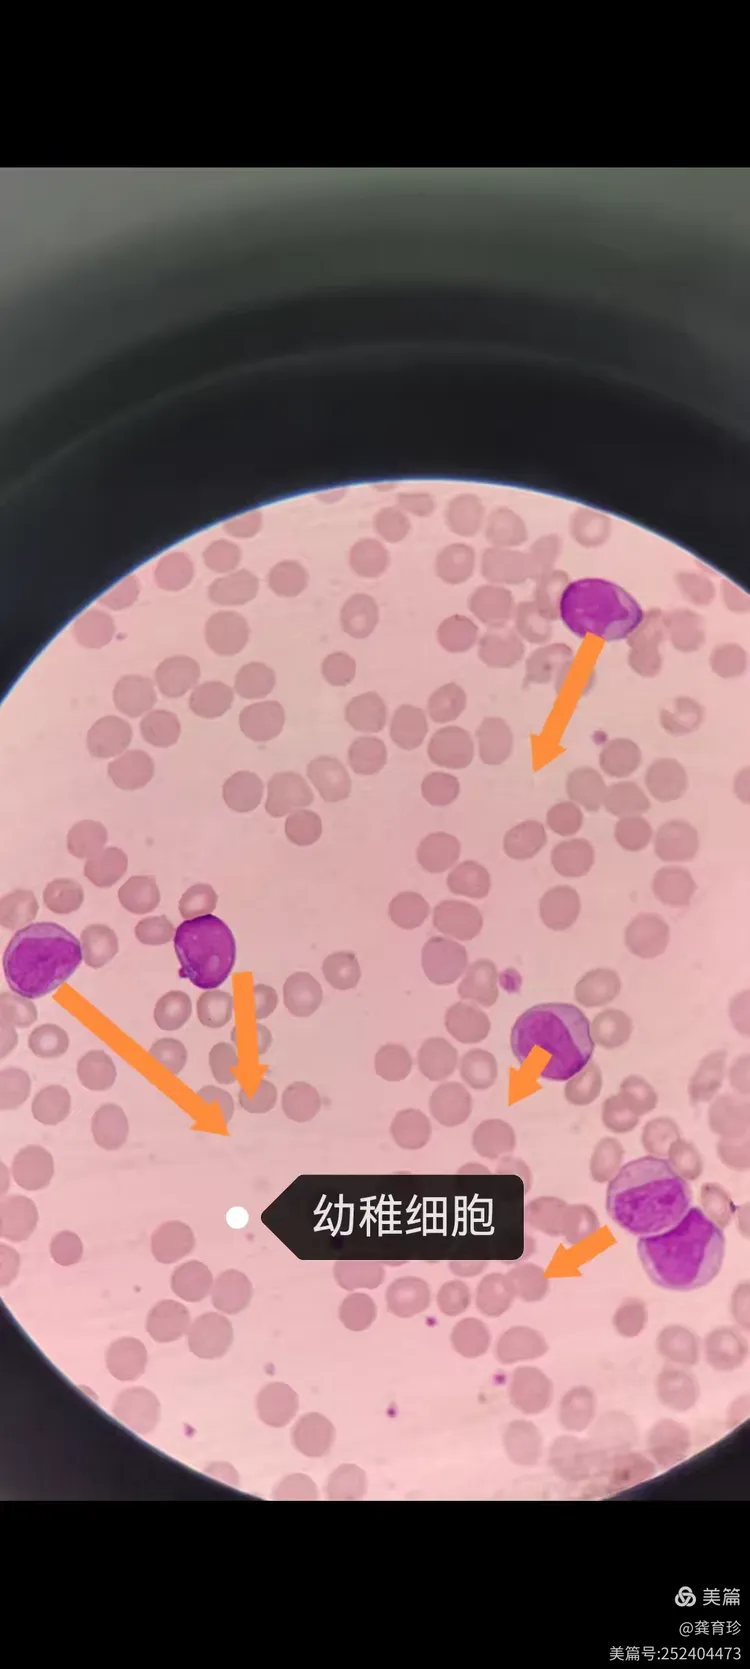
幼稚粒细胞

晚幼粒细胞图

中性晚幼粒细胞的形态特征与功能解析 🌱
图片尺寸1043x1013
🔬 晚幼红细胞探秘
图片尺寸800x1067
中性晚幼粒细胞血细胞形态学检查
图片尺寸1003x1337
—血细胞形态学检查 👉 🍀中性晚幼粒细胞
图片尺寸905x1207
🔬 细胞形态学:中幼粒细胞及以下阶段解析
图片尺寸2560x1809
骨髓片 图一指针晚幼红细胞,图三四指针中性中幼粒细胞
图片尺寸1080x1440
中性晚幼粒细胞
图片尺寸650x484
晚幼粒细胞,成髓细胞,髓细胞,吞噬细胞,单核细胞
图片尺寸1200x1086
🔬红细胞形态大揭秘:中晚幼红细胞的特点
图片尺寸1149x800
仔细观察:粒,单核,淋巴及浆系分化成熟的形态特点
图片尺寸1080x1077
早幼粒细胞
中幼粒细胞
晚幼粒细胞
成熟粒细胞
图片尺寸1080x1139
成髓细胞,晚幼粒细胞,髓细胞,吞噬细胞,海洋性贫血
图片尺寸1100x1142
正常各期粒细胞形态特点
图片尺寸1199x1438
💧中幼红细胞形态解析🔬
图片尺寸813x1058
幼稚粒细胞
图片尺寸750x1669
早幼粒细胞的特点和形态
图片尺寸813x1053
晚幼粒细胞→杆状核→分叶核
图片尺寸640x481
🔬 探索早幼粒细胞的奥秘 🔬
图片尺寸1920x2530
晚幼红细胞的特点与形态变化
图片尺寸954x924
幼稚粒细胞
图片尺寸1920x2560